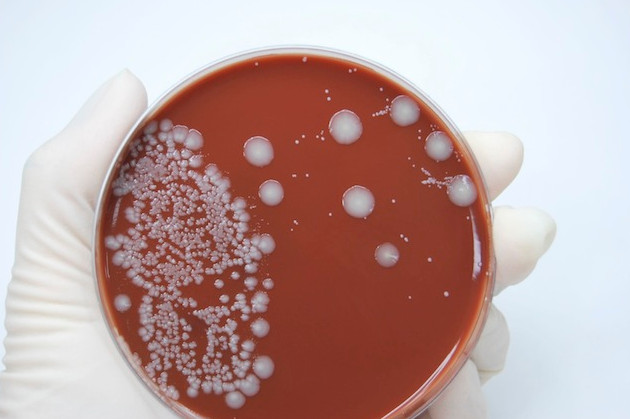
Менінгококовий сепсис або менінгококцемія симптоми у дітей і дорослих лікування можливість вижити

Етіологія або причини захворювання
Збудником менінгококової інфекції є грамнегативний мікроорганізм Neisseria meningitidis, що відноситься до диплококкам, тобто бактеріям округлої бобовидной форми, які утворюють пару. Менінгокок не має джгутиків і не може пересуватися, але має капсулу, яка забезпечує їй захист від фагоцитозу при попаданні в організм.
Спор не утворює. Даний вид інфекції є антропонозной, що означає передачу тільки від людини до людини. Менінгокок дуже нестійкий у зовнішньому середовищі, термін його життя поза організму людини становить близько півгодини.
Передається повітряно-крапельним шляхом, джерелом зараження служить хвора людина або безсимптомний носій. Відомо 12 серотипів збудника, частина з яких (A, B, C, W, X і Y) можуть викликати епідемічні спалахи.
Сприйнятливість до менінгококів досить висока і інфекція широко поширена, проте при інфікуванні хворіють не всі, а тільки люди з ослабленим імунітетом – за цієї причини захворювання більшою мірою схильні діти, в силу недостатньої зрілості імунної системи.
У більшості хворих менінгококова інфекція викликає гострий назофарингіт, який за своїм перебігом мало чим відрізняється від звичайного ГРЗ. При вдиханні повітряної суспензії, що містить Neisseria meningitidis, збудник потрапляє в ніс і/або рот, поширюється по носоглотці і викликає запалення, яке хоча і носить гострий характер, як правило, дозволяється протягом декількох днів.
Однак у деяких людей інфекція проникає в інші органи і системи, вражаючи їх, а у важких випадках приймає важку генералізовану форму. Менінгококи здатні долати гематоенцефалічний бар’єр, потрапляючи в головний мозок і вражаючи мозкові оболонки (менінгіт), а іноді і власне мозкову тканину (менінгоенцефаліт).
Основним чинником ризику, таким чином, є зниження захисних сил організму. Має значення також ускладнена епідемічна обстановка і скупченість, особливо в дитячих установах.
Відзначається деяка сезонність захворюваності – ризик захворіти підвищується у весняні місяці, хоча не є нульовим протягом усього року.
Після перенесеного захворювання формується досить стійкий імунітет, однак він має группоспецифический характер, що означає стійкість лише до одного серотипу збудника. Повторні випадки захворювання зустрічаються вкрай рідко, тим не менш, вони не виключені при інфікування менінгококом іншого серотипу.
Менінгококова інфекція викликається грамнегативних аэробом Neisseria meningitidis, розмір близько 1 мкм, в класичному випадку організми нагадують зерна кави або квасолі, розташовані попарно (диплококки), увігнутими краями один до одного, і розташовуються усередині клітин організму господаря.
Менінгококи дуже примхливі до живильному середовищі і вимагають людський білок або схожий набір амінокислот.
Антигени збудників підрозділяють на серогрупи A, B, C, усього 13 груп та 20 серологічних типів на підставі антигенних властивостей полісахаридів капсули. Саме вони відповідають за розвиток симптомів хвороби.
У Росії в XXI столітті поступово серотип А витісняється серотипом С. Крім того, з’являються «завезені» випадки серотипу W 135. Він називається «мусульманським», так як його завозять паломники з Мекки і Саудівської Аравії.
Визначення серотипу
Збудник дуже слабо стійка: швидко гине при високій і низькій температурі, не переносить сонячне світло, ультрафіолет, його вбиває за одну годину будь-дезінфікуючий засіб.
Розповімо про епідеміології менінгококової інфекції. Ця хвороба тільки людська, і джерело її тільки людина. Причому не тільки хворий, але і носій, який сам не знає про свою хворобу.
Найбільш заразні, звичайно, хворі явними і важкими формами, їх здатність до зараження в 5 разів вище, Чим у носіїв. Але головним джерелом існування в популяції захворювання є, звичайно, носії, так як їх, в середньому, в 10000 разів більше, Чим хворих.
Менінгококова інфекція передається повітряно – крапельним шляхом. Якщо є її поєднання та ГРВІ, виражений кашель, нежить, то розсіювання мікробів і ступінь контагиозности такого хворого зростає в рази.

Інфекція передається повітряно-крапельним шляхом
Стійкість до менінгококової інфекції слабка, і 50% випадків зустрічаються у дітей у віці до 5 років. Через особливості передачі захворюваність більш виражена містах, сім’ях (ризик захворіти члену сім’ї, який живе поруч з хворим, вище в 100 разів), замкнених колективах, гуртожитках і особливо казармах з єдиним залом для сну.
В кліматичній зоні чорноземної смуги Росії захворює 1 чоловік на 100 000 щорічно, число дітей на порядок вище. Менінгококова інфекція поширена по всіх країнах і континентах, виражена сезонність підвищення захворюваності з піком з кінця лютого по квітень (у північній півкулі).
Поширена менінгококова інфекція повсюдно. Через кожні 12-16 років спостерігаються підйоми захворюваності. Імунітет стійкий, але типоспецифічний. Про поширеність захворювання свідчить той факт, що до 30 років більш Чим 2/3 населення мають антитіла до менінгококу, отже, перехворіли в легкій формі.
Збудник
Менінгокок – це округла грамнегативна бактерія, нерухома, спор не утворює. У клітинах людини він розташовується попарно, формуючи структури, схожі за зовнішнім виглядом з кавовими зернами. Подібна організація бактерій називається диплококком.
Бактерії виділяють велику кількість агресивних речовин, що сприяють їх проникненню в кров і різні тканини організму. Наприклад, гіалуронідаза розщеплює основний компонент сполучної тканини – гіалуронову кислоту, завдяки чому відбувається розпушення колагенових пучків і формування проходу для менінгокока.
Клітинна стінка бактерій являє собою сильний токсин для організму людини. Він негативно впливає на центральну нервову систему, нирки, серцевий м’яз і викликає потужну активацію імунної системи.
Збудник нестійкий у зовнішньому середовищі. Він швидко гине при нагріванні, під дією ультрафіолетового випромінювання, при обробці дезінфікуючими засобами. Найбільш сприятливі умови для його життя – це висока вологість (70-80%) і температура повітря в діапазоні 5-15 градусів С, в них він зберігає свою активність до 5-ти діб.
Джерелом інфекції є хвора людина або носій. Носії менінгокока ніяк не проявляється суб’єктивно, тому людина не знає про те, що небезпечний для оточуючих. Збудник локалізується в носоглотці, виділяється назовні з крапельками слини при розмові, кашлі, чханні.
Відзначено, що при накопиченні носіїв близько 20% в популяції виникають масові спалахи менінгококової інфекції. Хворі на менінгіт або поширеною формою інфекції заразні, але вони, як правило, ізольовані від суспільства та становлять небезпеку тільки для доглядають за ними людей.
Форми захворювання
Хвороба може протікати у прихованій формі – бактеріоносійства. Бактеріоносійство виникає тоді, коли імунна система недостатньо сильна, щоб не допустити інфікування, але досить сильна для того, щоб не дати розвинутися захворювання.

Найбільш поширеною формою менінгококової інфекції, з якою стикаються більшість інфікованих, є гострий назофарингіт. Однак якщо збудника вдається подолати місцевий бар’єр, він потрапляє в кров і розноситься по всьому організму, купуючи генералізований характер.
У цьому випадку говорять про менінгококцемії, яка може призвести до менінгіту, менингоэнцефалиту або розвитку поєднаних форм (будь-які комбінації однієї або декількох генералізованих форм). Генералізовані форми менингоинфекции становлять 0,5% від усіх випадків инфицированния Neisseria meningitidis
Менінгококи, з током крові поширюючись по організму, здатні вразити не тільки носоглотку або мозкові тканини, але і віддалені органи і тканини – серце (міокардит), суглоби (артрит), райдужну оболонку очей (іридоцикліт) і т. д., проте це відбувається рідко.
Механізм розвитку хвороби
Менінгокок потрапляє на слизову оболонку носоглотки сприйнятливого людини і міцно закріплюється на ній. Подальше взаємодія макроорганізму і мікроорганізму залежить від активності імунної системи і агресивності токсинів збудника.
Якщо місцевий імунітет виражений добре, то розвивається носійство менінгококової інфекції: бактерії помірно розмножуються в носоглотці і в невеликих кількостях виділяються в зовнішнє середовище. Через якийсь час вони залишають організм.
Якщо вірулентності менінгокока достатньо, щоб проникнути вглиб слизової оболонки, розвивається менінгококовий назофарингіт. Бактерії руйнують клітини організму, виділяють в тканини агресивні речовини, що тягне за собою реакцію судин та імунної системи.
Кров посилено притікає до місця запалення, рідка частина виходить в слизову оболонку – формуються гіперемія і набряк. Вони покликані обмежити патологічний осередок і не допустити подальшого розповсюдження збудника.
Чутливі нервові закінчення в зоні запалення реагують на біологічно активні речовини, які виділяють зруйновані клітини і посилають в мозок больовий імпульс, як сигнал лиха. Його додатково підсилюють токсини бактерій і тиск набряклих тканин на рецептор. В результаті людина відчуває біль і першіння в горлі.
Якщо запальна реакція не зупинила менінгокока в носоглотці, він проникає в кровоносні і лімфатичні судини. У крові збудника атакують клітини імунітету і захисні білки, з-за чого значна частина мікроорганізмів гине з виділенням небезпечного токсину.

захворювання, що викликаються менінгококом
Якщо ж клітини імунітету розтрачують свій потенціал до того, як знищать всіх бактерій, то відбувається незавершений фагоцитоз. Лейкоцит захоплює менінгокока, але не може його перетравити, тому збудник залишається життєздатним і в такому вигляді подорожує по організму.
Подальший розвиток подій залежить від того, куди проникнуть бактерії. Проникнувши через мозкові оболонки, вони викликають менінгіт, через капсулу суглобів – гнійний артрит, у радужку очного яблука – іридоцикліт.
Менінгококи осідають в периферичних кровоносних судинах і ушкоджують їх судинну стінку з-за чого кров спрямовується в тканини. Так, формується геморагічний висип на шкірі, яка являє собою локальні крововиливи.
Велика кількість менінгококового токсину в крові призводить до паралитическому розширенню судин на периферії і різкого падіння артеріального тиску. Відбувається перерозподіл кровотоку: кров депонується в дрібних судинах і не надходить в достатній кількості до життєво важливих органів – головного мозку, серця, печінки. Розвивається інфекційно-токсичний шок – смертельно небезпечний стан.
Локалізовані форми:
- Носії менінгокока – протікає безсимптомно;
- Гострий назофарингіт – проявляється симптомами ГРЗ;
- Пневмонія – по клініці не відрізняється від інших бактеріальних пневмоній.
Генералізовані форми:
- Менінгококцемія – знаходження збудника в крові, один з варіантів розвитку – інфекційно-токсичний шок;
- Менінгіт – гнійне запалення мозкових оболонок, при приєднанні набряку і запалення головного мозку говорять про менінгоенцефаліт;
- Поєднана – поєднує менингококкцемию з менінгітом, це одна з найбільш поширених тяжких форм інфекції;
- Рідкісні форми – включають неспецифічні для менінгокока локалізації (ендокардит, артрит, іридоцикліт).
Стадії захворювання
Як у більшості інфекційних захворювань, у менингоинфекции є чотири основних стадії: латентна, початок хвороби, розпал і дозвіл, однак у деяких форм виражені не всі з них. Наприклад, транзиторна бактеріемія – безсимптомна форма менінгококцемії, яка має лише одну, латентну стадію, і виявляється випадково.
В інших випадках латентний період не проглядається, захворювання має гострий початок.
Стадія розпалу в більшості випадків завершується реконвалесценцией, або одужанням. Однак при важких генералізованих формах захворювання, таких як синдром Уотерхауза – Фрідеріксена, високий ризик летального результату.
Симптоми
Прояви менінгококової інфекції варіюються залежно від локалізації та тяжкості ураження, від повної відсутності при бактерионосительстве або місцевого запалення (наприклад, запалення суглобів) до інфекційно-токсичного шоку.
Назофарингіт, спричинена Neisseria meningitidis, починається гостро, температура тіла підвищується до субфебрильних значень (37,5-38 °С), з’являється біль під час ковтання, першіння в горлі, закладає ніс, пізніше виникає нежить.
Іноді хвороба має незначно виражені симптоми, зокрема, протікає без підвищення температури або з незначним підвищенням (37-37,2 °С).
Менінгококцемія
Менінгококцемія, або менінгококовий сепсис, може початися гостро, або бути наслідком несприятливого результату менінгококового назофарингіту. Найчастіше хвороба починається раптово, з появи нездужання, яке швидко наростає, підйому температури до гарячкових значень (38-39 °С), появи сильного головного болю.
Шкіра стає блідою з ціанотичним відтінком, хворий покривається холодним липким потом. До кінця першого дня хвороби зазвичай з’являється висип. Спочатку вона має вигляд розеол різного розміру, розташовується по всьому тілу, зникає, якщо на неї натиснути.
Пізніше з’являються вогнища геморагії, вони яскраво – або темно-червоні, розташовані над рівнем шкіри, переважно на нижній стороні тіла (спина, сідниці, стегна, гомілки, п’ятки). До кінця другого дня розеолезная висип зникає, а геморагічні вогнища, навпаки, збільшуються і темніють.
 Осередки геморагії при менінгококцемії
Осередки геморагії при менінгококцеміїЦе блискавична форма менінгококцемії, для якої характерно надзвичайно бурхливий перебіг, приводить до розвитку інфекційно-токсичного шоку. Зустрічається така форма порівняно рідко – на її частку припадає 10-20% генералізованої менингоинфекции. Має несприятливий прогноз.
Починається раптово, симптоматика наростає дуже швидко, значно страждає загальний стан пацієнта. Температура тіла дуже швидко піднімається до 40 °С і вище, артеріальний тиск спочатку трохи підвищується, потім знижується, з’являється тахікардія, порушується дихання.
Свідомість стає плутаним, згодом пацієнт втрачається. Можуть виникнути судоми. Швидко, протягом декількох годин з’являються шкірні геморагічні висипання. Елементи висипки швидко збільшуються в розмірах, зливаючись у великі геморагічні вогнища темного кольору, нерідко це відбувається буквально на очах.
Згодом температура тіла знижується, що є несприятливою ознакою, що свідчить про виснаження адаптаційних механізмів. Якщо пацієнт не отримає вчасно кваліфіковану медичну допомогу, захворювання закінчується летальним результатом.
Як і більшість інших форм менингоинфекции, починається гостро з підйому температури тіла до фебрильних значень, погіршення загального стану і появи інтенсивного головного болю. Біль посилюється при будь-яких подразники (шумових, світлових, тактильних), зміні положення тіла, рухи голови;
супроводжується нудотою і блювотою. Блювота, не пов’язана з прийомом їжі, може бути багаторазовою, полегшення після неї не настає. По мірі розвитку захворювання частішає серцебиття, виникає задишка, порушується свідомість, можуть з’явитися судоми, пацієнт впадає в кому.
Ця форма менингоинфекции хоча і має менш стрімкий розвиток, Чим блискавична менінгококцемія, без надання адекватної медичної допомоги може мати такі ж наслідки з-за розвиненого набряку мозку.
Діти, особливо першого року життя, що становлять найбільш вразливу групу щодо менингоинфекции, і сильніше, Чим дорослі, страждають від неї. Найбільш часто генералізовані форми захворювання розвивається саме у дітей раннього віку (до трьох років).
Початок хвороби раптове, часто батьки можуть з точністю назвати час появи перших симптомів. Починається з підйому температури до фебрильних значень, блювання, різке погіршення загального стану і появи сильного головного болю.
Немовлята реагують на це плачем, для якого існує спеціальний термін – мозковий крик, він має постійний монотонний характер. Дитина приймає вимушену позу, не дає доторкнутися до голови, негативно реагує на будь-які подразники. При появі таких симптомів слід негайно звертатися до лікаря.
Якщо у дитини або дорослої людини розвивається менінгококовий назофарингіт, то клінічна картина хвороби, як правило, схожа з назофарингітом при ГРЗ. Приблизно три дні у хворого може спостерігатися субфебрильна температура тіла.
Іноді підвищення температури тіла не відбувається взагалі. Людину турбує головний біль в помірному ступені, невелика закладеність носа. Не відзначається виражених катаральних явищ. Може також проявитися неяскрава гіперемія зіву, а на задній стінці глотки може бути доріжка з гною і слизу.
Для менінгококцемії характерно різке початок: стрибок температури тіла, яка зростає 38-39°С, сильні больові відчуття в суглобах і мишах, озноб, блювота, головні болі. Характерний симптом даного стану — геморагічний висип. Як правило, вона з’являється в першу добу хвороби або на початку другої доби.
При особливо важких формах захворювання така висип розвивається у людини буквально в перші години після початку хвороби. Фахівці вважають цей ознака несприятливим з точки зору прогнозу розвитку недуги.
Висип спочатку з’являється невеличкими плямами світло-рожевого кольору на кінцівках і тулубі людини. Іноді помилково таку висип приймають за прояви алергії. Трохи пізніше на місці плям розвиваються геморагії, які мають неправильні контури і, утворюючись на блідій шкірі, схожі з зображенням зоряного неба.

Така висип наслідує в основному нижню частину і бічні зони тулуба хворого, вона проявляється також на стегнах. Трохи пізніше висип стає більш темною, в центрі геморагій утворюються некрози. Поступово елементи висипу збільшуються, зливаються і вражають великі ділянки тіла.
В даному випадку це переважно кінцівки, пальці ніг і рук. Іноді прогресує некроз, наслідком якого стає суха гангрена носа, вушних раковин, фаланг пальців. Якщо висип з’являється на століттях, обличчі, вушних раковинах, то прогноз аналогічно несприятливий.
В процесі погіршення стану у людини може розвиватися різна ступінь інфекційно-токсичного шоку.
При гнійному менінгіті симптоми хвороби відразу виявляються гостро. Температура тіла хворого досягає позначки 39-40°С, іноді вище. В основному пацієнт скаржиться на дуже сильний головний біль, що поширюється до чола і потилиці.
Біль різко посилюється, стає абсолютно нестерпним. Людина страждає від нападів блювоти, при цьому нудоти він не відчуває. Якщо хворий приймає препарати, анальгетики, то вони дають тільки дуже слабкий ефект на короткий час. У такому стані у пацієнта виявляється гіперакузія, гіперестезія, світлобоязнь.
Якщо гнійний менінгіт проявляється у маленької дитини, то він, на відміну від перебування в інших хворобливих станах, не хоче йти на руки до мами, а залишається в ліжку, приймаючи завмерлу позу, так як головний біль стає сильнішою при будь-якому русі.
У немовляти при гнійному менінгіті напружується джерельце, хоча при дуже частої блювоти він може западати всередину. У перші години після початку захворювання дитина збуджена, пізніше він стає повільним і млявим. Малюк може втрачати свідомість, страждати від періодично проявляються судом.
При розвитку генералізованих форм менінгококової інфекції іноді прояв основних симптомів супроводжує розвиток ознак артриту і поліартриту. Суглоби, як правило, уражаються на одній стороні тіла. В основному відбувається ураження дрібних суглобів, рідше страждають великі.
Рідше менінгококова інфекція проявляється у формі ендокардиту, панофтальмита, іридоцикліту, перикардиту, пневмонії.
Клінічні прояви
З моменту зараження до появи симптомів менінгококової інфекції проходить від 1 до 10 днів, у середньому інкубаційний період триває 2-4 дні.
Назофарингіт
При огляді зіву видно гіперемія задньої стінки глотки, з 2-3 дня хвороби вона стає зернистою через реакції дрібних лімфоїдних фолікулів. Мигдалики, їх дужки, язичок залишаються незміненими, хоча у дітей молодше 3-х років запалення поширюється і на них.
Менінгококцемія
Знаходження менінгокока в крові викликає швидкий і потужний імунну відповідь, який негайно позначається на стані хворого. Починається захворювання гостро з різкого підвищення температури до 39 градусів і вище.
геморагічний висип при менінгококцемії
Через 6-24 години після підйому температури з’являється найхарактерніший ознака менингококкцемии – геморагічний висип. Спочатку вона може виглядати, як рожеві плями, точкові крововиливи, які швидко перетворюються в великі неправильної форми синці.
Елементи висипу мають різну форму і розмір, кілька вибухають над поверхнею шкіри, чутливі при торканні. Найчастіше вони розташовуються на стегнах, сідницях, стегнах і стопах і мають зірчасті обриси.
Висип підсипає протягом 1-2 доби, після чого починається зворотний розвиток її елементів. Дрібні пигментируются і повністю зникають через деякий час, великі можуть залишати після себе втягнуті рубці.
Раннє поява висипки (до 6-ти годин після підйому температури) і розташування її елементів на обличчі, верхній половині тулуба – це ознаки вкрай тяжкого перебігу менингококкцемии. Іноді вона закінчується некрозом кінчика носа, пальців кистей і стоп.
Знаходження менінгокока в крові загрожує розвитком грізного ускладнення – інфекційно-токсичного шоку. Зазвичай він починається в перші години від початку захворювання і без екстреної допомоги неминуче веде до загибелі хворого.
Перші ознаки початківця шоку – це мармурова блідість шкіри, зниження температури тіла і артеріального тиску. Хворий поступово втрачає свідомість і впадає в кому, смерть настає від недостатнього кровопостачання мозку, серця і печінки.
Ще одне небезпечне ускладнення менінгококцемії – це синдром Фрідеріксена-Уотерхауза. Воно розвивається при загибелі кори надниркових залоз під впливом масивного крововиливу в неї. У хворого припиняється вироблення гормонів надниркових залоз, які відповідають за водно-сольовий обмін і підтримання артеріального тиску. У підсумку він гине від зневоднення або серцевої недостатності.
Менінгіт
Менінгококовий менінгіт починається з підйому температури до 38,5-39,5 градусів С і головного болю, яка значно посилюється до кінця першої доби хвороби.

симптоми менінгіту
Біль в голові носить розпираючий характер, найчастіше локалізується в лобово-скроневій або потиличній областях, але може охоплювати і весь череп цілком. Больові відчуття посилюються від яскравого світла, голосних звуків, при зміні положення тіла.
перший ознака менінгіту у дитини
До кінця першої доби з’являються симптоми подразнення менингеальной оболонки (менінгеальні знаки). До них відносяться болючість задньошийних м’язів, неможливість повністю розігнути ногу в колінному суглобі при зігнутому тазостегновому.
У немовлят першими ознаками менінгіту вважаються повна відмова від їжі, постійний монотонний крик, вибухання тім’ячка на голові. Якщо взяти хворого малюка за пахви він підгинає ніжки до тіла – це симптом підвішування.
На 3-4 добу хвороби за відсутності антибактеріального лікування хворий займає характерну позу «лягавої собаки». Він лежить на боці, підігнувши ноги й закинувши голову назад, при цьому спина його сильно вигнута і напружена.

У дітей подібна поза зустрічається частіше і виражена більш яскраво, Чим у дорослих. До цього ж часу каламутніє свідомість, хворий загальмований, не реагує на запитання відповідає односкладово. У деяких випадках відключається слух, розвивається параліч очних яблук, кінцівок, ковтальних м’язів.
Можливі ускладнення
Тяжкість перебігу хвороби, а також одужання безпосередньо залежить від того, чи була забезпечена своєчасна діагностика і правильний підхід до лікування. Якщо хворого привозять на лікування у стаціонар тільки через добу після появи перших ознак хвороби, то таке звернення вважається пізнім.
Отже, різко зростає ймовірність прояви ускладнень, а також ризик несприятливого результату. Але якщо лікування було розпочато вчасно і проведено правильно, то хворий повністю одужує.
В якості ускладнень недуги може проявитися поразку слухових нервів, що згодом стає причиною приглухуватості. У грудних малюків часто виявляються ускладнення, які мають бактеріальний характер.
Високим ризиком розвитку ускладнень характеризуються генералізовані форми менингеальной інфекції. Вогнища некрозу, що розвиваються при менінгококцемії, можуть вражати великі ділянки, наприклад, кінцівки, що призводить до їх ампутації.
Перенесений менінгіт може мати довгострокові наслідки у вигляді різних неврологічних порушень. Найбільш грізним ускладненням генералізованої менингоинфекции є інфекційно-токсичний шок з надниркової недостатністю, який з високим ступенем ймовірності призводить до загибелі пацієнта.